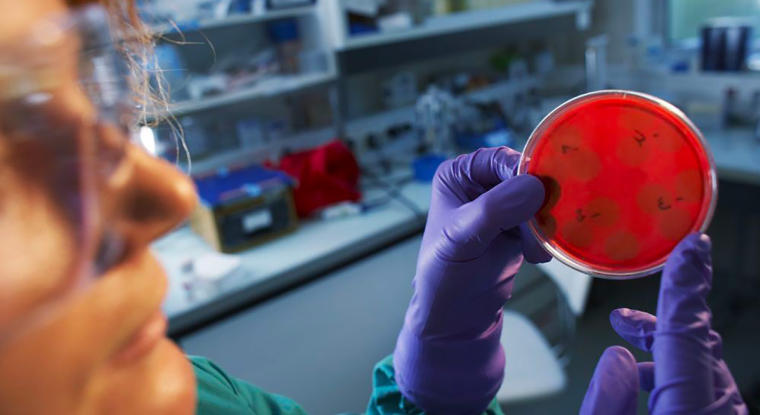
Le leader mondial des vaccins compte passer de 7 à 10 milliards d’euros de chiffre d’affaires cette année. (© Sanofi)

Le leader mondial des vaccins compte passer de 7 à 10 milliards d’euros de chiffre d’affaires cette année. (© Sanofi)
Mis au défi par la communauté des investisseurs de présenter des relais au Dupixent, le leader mondial des vaccins compte passer de 7 à 10 milliards d’euros de chiffre d’affaires dans le domaine en huit ans.
Son actualité: deux mois après avoir annoncé que le Dupixent, son médicament phare contre le prurigo nodulaire, dépasserait 10 milliards d’euros de chiffre d’affaires dès cette année, la direction de Sanofi indique qu’elle compte dépasser ce même seuil pour l’ensemble de sa branche vaccins en 2030.
Elle mise sur ses développements technologiques – dont l'ARN messager – dans ses domaines forts que sont la grippe, la méningite, les vaccins pédiatriques et les infections à virus respiratoire syncytial (VRS).
Notre analyse«Le premier et principal enjeu, reste le lancement du Beyfortus, un vaccin contre le VRS chez le nourrisson», estiment les analystes d'Oddo BHF, un marché estimé à 8 milliards de dollars en 2030, dont Sanofi compte conquérir 30%.
«Le dossier clinique est réellement robuste avec une réduction de 83% des hospitalisations et une sécurité d’emploi excellente. Sanofi est prêt pour un envoi des commandes dès cette année», soulignent-ils.
Une raison supplémentaire de conserver cette valeur en portefeuille, raisonnablement valorisée (11,7 fois le bénéfice net estimé pour 2023) et dont le rendement ressort à 4,1%.
Conservez. [SAN] Objectif : 105 euros. Profil : prudent.
Prochain rendez-vous : résultats du second semestre, le 28 juillet.
Source LeRevenu.com




0 commentaire
Vous devez être membre pour ajouter un commentaire.
Vous êtes déjà membre ? Connectez-vous
Pas encore membre ? Devenez membre gratuitement
Signaler le commentaire
Fermer